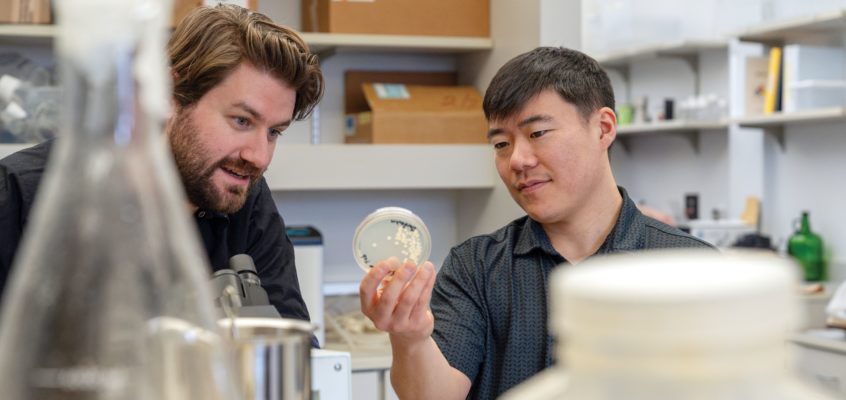
Students looking into a petridish containing some form of culture.

In the fall of 2023, Miles Koons tended the taps at Ellensburg Brewery, pouring frothy pints of beer brewed by his fellow CWU Brew Club members for his patrons. His job as the brewery’s taproom manager helped him grow closer to the community of brewing professionals and aficionados in Central Washington who inspired him to pursue a craft brewing degree in the first place.
“The ability to practice our craft in a brewery setting under the guidance of an experienced brewer, with free rein to explore the beers we’re interested in and see them get sold, that’s something we’ll never take for granted,” Koons said of the downtown Ellensburg restaurant, which discontinued its brewing operations in January. “Seeing the whole life cycle of a beer and having an active hand in it is incredible.”
As current vice president of the CWU Brew Club, Koons works with the Craft Brewing program, as well as local brewers and hop growers, to develop the hands-on experiences that set graduates of the program apart from the competition in the
Pacific Northwest.
For two years, the brew club worked closely with Ellensburg Brewery to produce its own beers in the professional brewing facility and then sell them in the taproom. Even though the partnership has ended, this hands-on experience allowed students to see the results of their experimentation in terms of sales and customer satisfaction.
Ellensburg Brewery’s former Head Brewer Eric Foss helped facilitate this collaboration, in the spirit of keeping innovation alive.
“I loved working with students and maintaining that connection to CWU,” said Foss, also a former Craft Brewing lecturer at Central. “We got more variety on tap, and they got to brew in a professional environment. There are a lot of habits that you can only really develop through practice, and through messing up once or twice. Having opportunities like this will produce some really well-rounded brewing professionals.”

An Art and a Science
Getting in the habit of using industry-grade machinery with the precision and care that it demands is half of the two-pronged approach employed by the Craft Brewing program, which became the only four-year degree of its kind in the Northwest in 2018.
Director Geoff Sasaki says the curriculum is designed to marry science with art in a practical setting, creating the multi-talented professionals the booming craft beer industry needs.
“We put the science first, then let the art follow once students have command of the basic principles,” Sasaki said. “The process of hypothesizing and experimentation at a brewery isn’t so different from what happens in a lab, and being able to approach it with that lab-like precision will ultimately make a better product.”
As Craft Brewing Lab Technician Brian Labore noted, that depth of knowledge has proven extremely helpful to businesses across the region. It’s also one of the reasons why CWU Craft Brewing boasts a 100% job placement rate for graduates.
“A solid science background with practical training means our students can show up at a brewery on day one and know how everything works,” Labore said.
Cole Provence, a lecturer in Craft Brewing and Wine Studies, worked with Foss to recalibrate the Craft Brewing program’s curriculum in 2019. In response to numerous industry changes, they redesigned the class offerings around collaboration with regional and national business leaders.
“What we were hearing was that hop and beer companies in Yakima, as well as across the state, were having real trouble finding qualified entry-level employees,” Provence said. “That’s when we realized we needed to work much closer with them to provide the kinds of students that the industry needed.”
In doing so, they discovered that CWU’s strength lies in the focus of its program, which is a full-fledged four-year bachelor’s degree in brewing, as opposed to the brewing-specialized biology degrees offered elsewhere.
“We thought to ourselves that if other universities were already doing a great job producing microbiologists, why should we compete with them?” Provence said. “At other programs in the U.S., students were complaining that they didn’t even get to brew their first batch of beer until their senior year. We wanted to make sure they got their hands on the equipment and started brewing as early as possible, so they’d really have an intuitive feel for it by the time they graduated.”
Graduates of the program are in high demand, sporting the well-practiced skillset and intimate knowledge of the brewing process required to make a dent on the densely packed playing field of the modern brewing scene that has blossomed along the entire West Coast over the past 15-20 years.
“Our reputation started growing in 2019-2020, when we had our first graduating class of 20 or so students from our revamped curriculum,” Provence said. “After they went out and started making their mark, suddenly every brewer in Washington came to us and asked if we had any students looking for work, even during the pandemic.”
Right Place at the Right Time
That network, coupled with CWU’s proximity to Yakima, gives graduating students immediate access to the combined connections and experience of brewers working in top positions across the country. Justin Paden (’19), a brewing and sensory science team member at Hopsteiner Research, saw his career take off after leveraging those advantages.
“I got my first internship in Yakima through the Craft Brewing program, and that really set me on the path I’m on today,” Paden said. “It gave me a great introduction to the industry, and showed me that the stuff I had learned in my studies was going to translate just fine into the real-world beer market.”
The Yakima Valley produces a staggering 40% of the world’s hops, an essential ingredient in brewing many popular varieties of beer. The three biggest hop companies in Yakima (Hopsteiner, John I. Haas, and Yakima Chief) are always looking for new talent to drive their businesses forward.
A number of CWU alumni are represented in top research positions, including Jeff Barnes (’15), who serves as brew master at Haas’ Innovations Brewery. Having completed his craft brewing certificate, Barnes walked off the commencement stage and straight into a career, thanks to high demand and robust networking.
“I quite literally graduated on a Saturday and started my work with Haas that Monday,” he said. “The program had already laid the groundwork for me, reaching out to the big hop companies and other craft breweries in the region to help me set the stage for a smooth transition.”
The rapidly growing network of CWU alumni in the beer industry is actively helping new graduates get their foot in
the door.
“We all keep in touch and help each other out in whatever ways we can,” Barnes said. “I always try to do a tour for CWU students during our harvest, and I know my fellow alumni at the other hop companies pitch in, too. We know that we’re an invaluable resource for students, just as much as students bring fresh perspectives and ideas to our work that we need to keep moving forward.”
The CWU Brew Club goes to the Yakima Fresh Hop Ale Festival every year to show off their product and learn from their fellow brewers. Craft Brewing senior and Brew Club officer Cameron Nelson says, in the end, this opportunity to put class and practice together is what it’s all about.
“As a brewing student, everyone tells you to get as much hands-on time as possible—just brew, brew, brew and then brew some more,” he said. “This is absolutely the best way of doing that. We get to work on professional-grade equipment and see our products on the shelf, along with getting feedback from actual customers and beer-lovers. It turns out we make pretty good beer.”